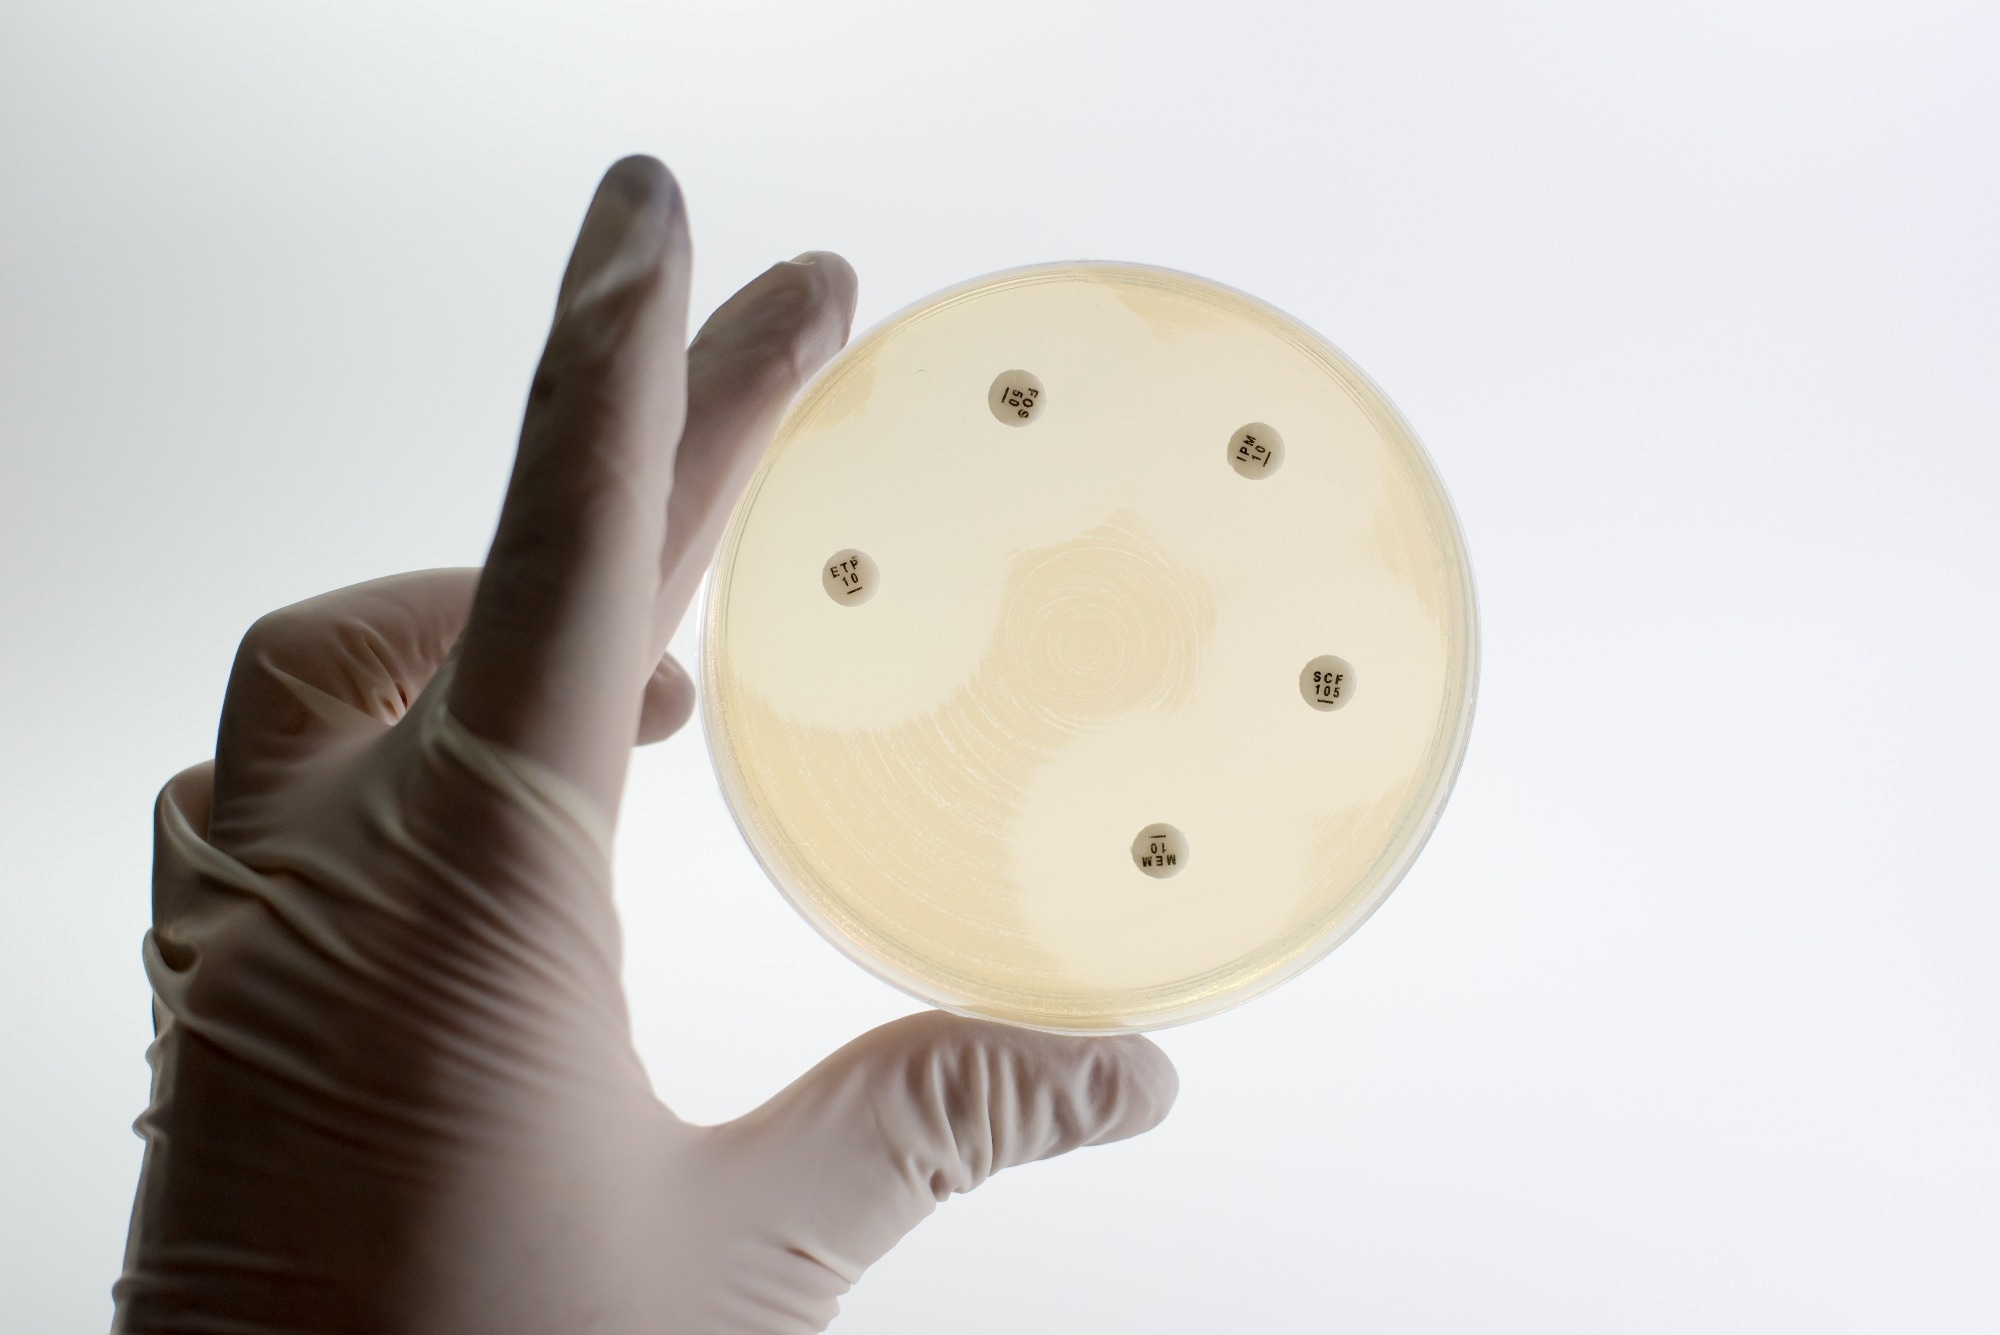
Drug sensitivity test, disk drug

A new study shows that ordinary painkillers, when taken alongside antibiotics, can drive dangerous mutations in bacteria, revealing how polypharmacy in older adults could be quietly promoting the global antimicrobial resistance crisis.
Study: The effect of commonly used non-antibiotic medications on antimicrobial resistance development in Escherichia coli. Image credit: NonSitth/Shutterstock.com
Study: The effect of commonly used non-antibiotic medications on antimicrobial resistance development in Escherichia coli. Image credit: NonSitth/Shutterstock.com
A recent study published in Npj Antimicrobials and Resistance investigated whether commonly used non-antibiotic medications (NAMs), particularly ibuprofen and acetaminophen, in residential aged care facilities (RACFs), enhance ciprofloxacin-induced mutagenesis in Escherichia coli. The study also assessed other widely used NAMS, including diclofenac and furosemide, which influenced resistance development even when they did not increase mutation frequency.
The impact of antimicrobial resistance on public health
AMR occurs when microbial organisms, such as bacteria, viruses, fungi, and parasites, no longer respond to antimicrobial medicines. Antimicrobials, such as antibiotics, antiparasitics, antivirals, and antifungals, are medicines used to prevent and treat infectious diseases in humans, animals, and plants.
The emergence and spread of antimicrobial-resistant organisms and resistance genes are a significant public health threat. In 2019, 4.95 million deaths worldwide were linked to antimicrobial resistance.
Antibiotics and non-antibiotics in the rise of antimicrobial resistance
A combination of various factors contributes to the development of AMR. Overuse of antibiotics in clinical and agricultural settings commonly leads to AMR development. In addition to antibiotics, NAMs (e.g., statins, diuretics, and proton-pump inhibitors) also contribute to the rise of AMR. Currently, 95% of medicines in the global pharmaceutical market are non-antibiotic drugs.
A recent study revealed that over 200 commonly used NAMs have antibiotic-like effects on gut bacteria. Statins, for example, have antibacterial activity, while certain nonsteroidal anti-inflammatory drugs (NSAIDs) promote cross-resistance development.
Bacteria may acquire a resistance mechanism during transformation via plasmids expressing resistance factors. Diclofenac is an NAM that increases the transformation efficiency, which increases the risk of developing resistance. Certain antibiotics (e.g., ciprofloxacin, a fluoroquinolone) and non-antibiotics (e.g., tramadol) are not completely degraded and introduced into wastewater through urine and/or stool excretion. Considering how frequently NAMs are used, it is essential to assess their potential in the development of AMR.
Many older people are highly dependent on medicines to manage chronic disease, and some even take nine or more prescribed drugs per day. This phenomenon is referred to as polypharmacy. The older population has been associated with higher antibiotic intake. Previous studies have indicated antibiotic overuse among RACFs, particularly in managing urinary tract and respiratory infections. For instance, clinicians commonly prescribe ciprofloxacin to older people to treat urinary tract infections (UTIs), which has led to the incidence of ciprofloxacin resistance and ciprofloxacin-resistant Escherichia coli among RACFs.
About the study
The current study investigated nine NAMs commonly used by older people: ibuprofen, diclofenac, acetaminophen, furosemide, pseudoephedrine, atorvastatin calcium, metformin, temazepam, and tramadol. Since these medicines are frequently co-administered with antibiotics, mutation frequencies were determined in the presence of ciprofloxacin, a known mutation inducer.
Mutation frequencies were assessed in E. coli BW25113 and E. coli 6146, antibiotic-sensitive strains isolated from a retirement resident. All assays to determine whether NAM exposure induces mutation within E. coli were carried out on plates supplemented with 0.015 µg/ml ciprofloxacin. The current study also analyzed mutation frequencies in the presence of two NAMs and ciprofloxacin.
Study findings
None of the NAMs assessed in this study exhibited antimicrobial activity against E. coli BW25113 and E. coli 6146, even at the highest tested concentration of 512 μg/mL. E. coli BW25113 and E. coli 6146 cell growth was analysed in the presence of sub-inhibitory concentrations of ciprofloxacin and/or gut concentrations of the NAMs.
Compared to non-exposed cells, those exposed to NAMs alone did not impact the growth of E. coli cells. However, for both E. coli isolates, the growth rate was significantly affected at about three-quarters of ciprofloxacin's minimum inhibition concentration (MIC). In the presence of three-quarters, the MICs of ciprofloxacin, ibuprofen, diclofenac, and acetaminophen enhanced the growth rates of E. coli BW25113. These three NAMs also reduced the length of the lag phase. In E. coli 6146, ciprofloxacin exposure delayed exponential growth, although certain NAM combinations modestly improved adaptability.
Higher mutation frequencies were observed in E. coli BW25113 and E. coli 6146 exposed to ibuprofen and acetaminophen than those exposed to ciprofloxacin alone. E. coli 6146 exposed to pseudoephedrine, temazepam, and tramadol significantly decreased the mutation frequencies, compared to ciprofloxacin only.
The current study observed that NAM exposure elevated ciprofloxacin resistance in select isolates. A higher mutation frequency was observed in cells following exposure to ibuprofen and ciprofloxacin. Furosemide/ciprofloxacin (Frs_M1) increased 32-fold for ciprofloxacin MIC and 16-fold for levofloxacin MIC. Ator_M4 (atorvastatin/ciprofloxacin exposed) and Dic_M4 (diclofenac/ciprofloxacin exposed) mutants revealed a 16-fold increase in ciprofloxacin MIC.
Notably, mutants derived from E. coli 6146 indicated significant resistance against levofloxacin, ciprofloxacin, and cefepime compared to the BW25113 strain. In some two-NAM exposures, resistance rose even higher, with ibuprofen plus diclofenac producing a 64-fold increase in ciprofloxacin MIC.
No significant effect was observed in the growth of E. coli BW25113; however, a modest effect was found on the growth of E. coli 6146 cells when exposed to ibuprofen- and acetaminophen-based NAM combinations in the absence of ciprofloxacin. The current study revealed that certain NAM combinations could increase bacterial strains' adaptability, fitness, and mutation frequencies. Notably, while two NAMs did not synergistically increase mutation frequency, mutants derived from two NAMS plus ciprofloxacin showed higher levels of ciprofloxacin resistance than those exposed to a single NAM.
BW25113-derived mutant M1 possessed a unique substitution mutation in SoxR (R20L). Many distinctive deletions in the MarR regulator were also detected among mutants. Specific mutants exposed to two NAMs exhibited more than one mutation, an increased mutation rate, and an increased mutation frequency. Experimental studies have demonstrated that resistance is mediated by efflux through the RND-type efflux pumps.
The study confirmed this by showing that resistance could be partially reduced in some mutants or fully reversed in others with an efflux pump inhibitor. RT-qPCR demonstrated substantial overexpression of the AcrAB-TolC efflux pump in several mutants. In addition to quinolones, some mutants showed reduced susceptibility to minocycline and ceftazidime, though these effects were less consistent.
Conclusions
The current study indicated that common medicines, such as acetaminophen and ibuprofen, when combined with ciprofloxacin, significantly increase mutation frequency and lead to multiple antibiotic resistance. Other NAMs, including diclofenac and furosemide, also contributed to higher resistance levels, even if they did not always elevate mutation frequency.
The authors emphasize that polypharmacy in aged care settings may amplify these risks and highlight the need to reassess medicine combinations, rather than issuing direct prescribing guidance.
Download your PDF copy now!
Journal reference:
- Chen, H. et al. (2025). The Effect of Commonly Used Non-antibiotic Medications on Antimicrobial Resistance Development in Escherichia Coli. Npj Antimicrobials and Resistance. 3(1), pp. 1-15. doi: https://doi.org/10.1038/s44259-025-00144-w https://www.nature.com/articles/s44259-025-00144-w